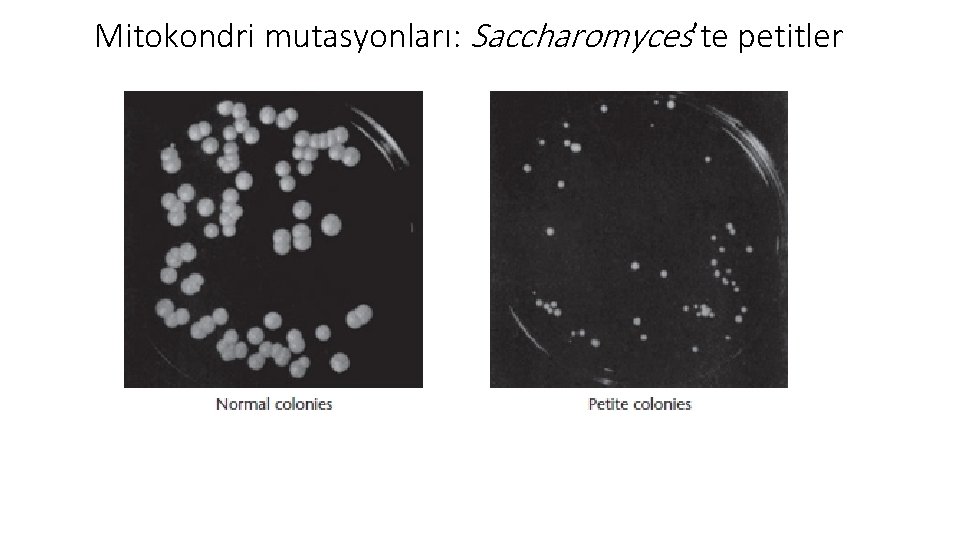
Mitokondri mutasyonları: Saccharomyces’te petitler

ekirdek D Kaltm Dr Hilal AY Organel kaltm

























- Slides: 25

Çekirdek Dışı Kalıtım Dr. Hilal AY

Organel kalıtımı Çekirdek dışı kalıtım Enfeksiyon tipi kalıtım Anasal etki

Kloroplast • Bu organellerin işlevleri hem çekirdek hem de organel DNA’sının gen ürünlerine bağlıdır. • Yavru bireylere çok sayıda organel geçişi Organel kalıtımı olur. • Bu durumda, organellerden sadece biri veya çok azı mutant bir gene sahipse, bu mutant genle ilgili mutant fenotip gözlenmeyebilir. Mitokondri

Kloroplastlar: akşam sefası bitkisinde renk çeşitliliği Polen kaynağı Beyaz dallar Yeşil dallar Alacalı dallar Tohum taslağının yerleşim yeri Beyaz dallar Yeşil dallar Alacalı dallar Beyaz Yeşil Beyaz, yeşil veya alacalı

Chlamydomonas’ta kloroplast mutasyonları Şekil. Yeşil alg Chlamydomonas’ın streptomisin dirençli (str. R) ve streptomisin duyarlı (str. S) suşları arasındaki karşılıklı çaprazlama sonuçları

Mitokondri mutasyonları: Neurospora’da poky örneği Özellikle elektron transportu için gerekli olan bazı sitokrom proteinlerinin yokluğu Mitokondri işlevinin bozulması Şekil. Ekmek küfü Neurospora crassa’nın gelişimini gösteren mikrograf Poky

Mitokondri mutasyonları: Neurospora’da poky örneği • Yabanıl tip ve poky suşları arasında yapılan çaprazlamalar, yavaş büyüme özelliğinin anadan geçen kalıtım sonucunda ortaya çıktığını göstermiştir. • Eğer dişi ebeveyn poky ve erkek ebeveyn yabanıl tip ise tüm yavru koloniler poky olmaktadır. • Karşılıklı çaprazlamalar ise normal yabanıl tip koloniler oluşturmaktadır. • Poky mutantları ile yapılan çalışmalar, bazen farklı misellerdeki hiflerin birbirileri ile kaynaşmasının aynı sitoplazmada iki veya daha fazla çekirdek bulunan yapıların ortaya çıkmasına neden olduğunu göstermiştir. • Eğer hifler, genotipi farklı olan çekirdekleri içeriyorsa bu yapıya heterokaryon denir. • Sitoplazma, başlangıçtaki iki miselden gelen mitokondrileri içerecektir.
Mitokondri mutasyonları: Saccharomyces’te petitler

Mitokondri mutasyonları: Saccharomyces’te petitler Şekil. Mayalardan Saccharomyces cerevisiae’da mitokondri işlevini etkileyen üç tip petit mutasyonun çaprazlanmasıyla elde edilen sonuçlar

Organel DNA’sı ve Endosimbiyotik Teori Şekil. Maruldan elde edilmiş kloroplast DNA’sının elektron mikrografı Şekil. Xenopus laevis’ten elde edilmiş mitokondri DNA’sının elektron mikrografı

Kloroplast DNA’sının moleküler organizasyonu ve gen ürünleri • 100 – 225 kb • Halkasal, çift iplikli, yarı-korunumlu replikasyon • Çekirdek DNA’sı ile benzer yoğunlukta ve baz içeriğine sahip • Genler içerisinde ve genler arasında kodlama yapmayan uzun nükleotit dizileri • Duplike genler • Kloroplast DNA’sı tarafından kodlanan birçok gen translasyonda rol alır. • t. RNA ve kloroplast ribozomlarına özgü proteinleri kodlayan genler vardır. • Kloroplast ribozomlarının sedimentasyon katsayısı 70 S’ten biraz küçüktür. Şekil. Marchantia polymorpha kloroplast DNA’sı tarafından • Rubisco – çekirdek ve kloroplast genleri tarafından kodlanır. kodlanan genlerin düzenlenişi

Mitokondri DNA’sının moleküler organizasyonu ve gen ürünleri • Çoğunlukla çift iplikli ve kapalı halkasal yapıdadır. • Yarı-korunumlu replike olur. • Ökaryotik DNA’nın aksine proteinlerle ilişkili değildir. • İntronlar yoktur (Saccharomyces mt. DNA’sında intronlar vardır). • Gen tekrarları nadiren görülür. • Replikasyon, çekirdek DNA’sı tarafından kodlanan enzimlerle yapılır. • mt. DNA’da t. RNA, r. RNA ve oksijenli sonlunum için gerekli olan polipeptidler kodlanır. • mt. DNA ağır (H – heavy ) ve hafif (L – light) ipliklerden oluşur. Şekil. İnsan mt. DNA’sında kodlanan genlerin düzenlenişi

Mitokondri DNA’sının moleküler organizasyonu ve gen ürünleri Şekil. Mitokondri işlevleri için gerekli olan gen ürünleri. Organele girdiği gösterilen ürünler sitoplazma kökenlidir ve çekirdek genleri tarafından kodlanmıştır.

İnsanda mitokondri DNA’sındaki mutasyonlar hastalıklara neden olur mt. DNA Oksijenli solunum için gerekli olan 13 protein Translasyon için gerekli olan 22 t. RNA Translasyon için gerekli olan 2 r. RNA • Gelişimin erken döneminde, hücre bölünmesi, zigotta bulunan başlangıçtaki mitokondri topluluğunun dağılımını sağlar ve yeni oluşan hücrelerde bu organeller bağımsız olarak çoğalır. • Bu nedenle, eğer başlangıçtaki organel grubunda zararlı bir mutasyon varsa ya da ortaya çıkarsa, erginler normal ve anormal organellerin karışımına sahip olur. • Bu duruma heteroplazmi denir.

İnsanda mitokondri DNA’sındaki mutasyonlar hastalıklara neden olur İnsanda görülen bir hastalığın, genetik olarak değişmiş mitokondriler sonucu olduğuna karar verebilmek için bazı kriterler vardır: Kalıtım, Mendel kalıtımı yerine anasal (maternal) kalıtım göstermelidir. Hastalık, organelin biyoenerjik işlevindeki eksikliğini yansıtmalıdır. Mitokondri genlerinden bir veya birden fazlasında özgül bir genetik mutasyon olmalıdır.

İnsanda mitokondri DNA’sındaki mutasyonlar hastalıklara neden olur Miyoklonik epilepsi Kearns-Sayre sendromu Mitokondriyal hastalıklar Leber kalıtsal optik nöropati Düzensiz kırmızı lif hastalığı

İnsanda mitokondri DNA’sındaki mutasyonlar hastalıklara neden olur Şekil. Mitokondri hastalıklarına sahip insanların iskelet kas hücrelerindeki düzensiz kırmızı fibriller. (a) orta derecede çoğalmış kas fibrilleri. (b) önemli oranda çoğalma sonucunda çoğu hücre yapısının mitokondrilerce kaplanması

Anasal (maternal) etkide, gelişimin erken safhalarında maternal genotipin güçlü bir etkisi vardır • Anasal etki durumunda, dişi gametlerdeki genetik bilgi transkripsiyona uğrar ve genetik ürünler (ya protein şeklinde ya da henüz translasyona uğramamış m. RNA şeklinde) yumurta sitoplazmasında bulunur. • Döllenmeyi takiben bu ürünler, erken gelişim sırasında ortaya çıkan özellikleri etkiler. Ephestia’da pigmentasyon Limnaea’da kıvrılma Drosophila’da embriyonik gelişim

Ephestia’da pigmentasyon Şekil. Un kurdu Ephestia kuehniella’da göz pigmentlerinin kalıtımında anasal etki. Larvanın ön kısmının her iki tarafında bulunan göz yapıları.

Limnaea ’da kıvrılma Şekil. Bir salyangoz olan Limnaea peregra’da kabuk kıvrılmasının kalıtımı. Kıvrılma ya sağa (dekstral) ya da sola (sinistral) yönelik olabilir. Anasal etki II. ve III. nesilde açıkça görülmektedir. Yavru döllerin kendi genotiplerinden ziyade, anasal ebeveynin genotipi, yavruların fenotipini kontrol etmektedir.

Drosophila’da embriyonik gelişim • Drosophila melanogaster’in embriyonik gelişimini kontrol eden çeşitli genlerin anasal etki gösterdiği ortaya çıkarılmıştır. • Anasal-etkili genlerin protein ürünlerinin işlevi, sırası gelince başka genleri aktive edecek olan genleri aktive etmektedir. • Bu tip gen aktivasyon silsilesi, normal embriyo oluşumunu ve bunun sonucunda da normal ergin sineklerin gelişmesini sağlar. • Anasal-etkili genlerin, olgunlaşan yumurtalar tarafından sentezlenen ürünleri vardır ve bu ürünler döllenme öncesi oosit içerisinde depolanır. • Döllenmeyi takiben bu ürünler, gelişim süresince uzamsal organizasyonu belirleyen moleküler tabakalaşmayı oluşturmaktadır.

Drosophila’da embriyonik gelişim • Drosophila’da bicoid geni (bcd) sineğin ön kısmının gelişiminde rol alır. • Homozigot mutant analardan (bcd- / bcd-) türemiş embriyolarda, normalde ergin sineğin baş ve göğüs kısmını oluşturacak olan anterior bölgenin gelişimi olmaz. • En azından bir tip yabanıl allel (bcd+) içeren analardan oluşan embriyolar, genotipleri bu mutasyon bakımından homozigot olsa da normal gelişim gösterirler. Şekil. Drosophila’nın erken gelişim döneminde • Anasal etki kavramı ile uyumlu olarak, yavruların fenotipi, embriyonun ön tarafında yoğunlaşmış bicoid embriyonun genotipi tarafından değil, dişi ebeveynin m. RNA genotipi tarafından belirlenir.

Enfeksiyon kalıtımı, konak organizma ile onun istilacısı arasındaki simbiyotik ilişkiye dayanır • Ökaryotlarda, sitoplazmik olarak aktarılan fenotiplerin birçoğu, bir mikroorganizma veya partikül istilası nedeniyle meydana gelir. • Simbiyotik ilişki içinde bulunan yabancı istilacı, yeni döllere ya da organizmalara genellikle ananın ooplazmasından geçer ve özgül bir fenotip oluşturur.

Paramecium’da kappa Şekil. Paramecium’un Katil (KK) ve duyarlı (kk) suşları arasında, konjugasyon sırasında sitoplazma alışverişinin olduğu ve olmadığı çaprazlama sonuçları. Kappa partikülleri (noktalar) sadece K alleli varsa oluşabilir.

Drosophila’da enfeksiyon partikülleri • Drosophila’da enfeksiyon kalıtsallığına iki örnek verilerbilir: CO 2 duyarlılığı ve eşey oranı. • Birincisinde, normalde CO 2 anestezisinden sonra iyileşen sinekler kalıcı felç olur ve CO 2 etkisiyle ölür. Duyarlı analar bu özelliklerini tüm yavrulara geçirir. Ayrıca, duyarlı sineklerin özütleri dirençli sineklere enjekte edildiği zaman bu özellikler dirençli sineklere de geçer. • Enfeksiyon partiküllerinin ikinci örneği ise D. bifasciata ile yapılan çalışmalarla ortaya çıkarılmıştır. Bu sineklerin büyük bir kısmı 21°C ve daha düşük sıcaklıklara maruz kaldıkları zaman çoğunlukla dişi yavrular oluşturmaktadır. Tayin edilmiş eşey oranı olarak belirtilen bu durum, dişi yavrulara geçirilir, fakat düşük oranda ortaya çıkan erkek yavrulara geçirilmez. • Bu sineklerde tayin edilmiş eşey oranlı dişilerin ooplazmasının normal dişilerin abdomenine enjeksiyonu ile bu özelliğin ortaya çıkması, eşey-oranlı fenotipten kromozom dışı bir elementin sorumlu olduğunu göstermektedir. Bu etken izole edilmiş ve bir protozoa olduğu gösterilmiştir. Bu protozoa hem dişilerde hem de erkeklerde bulunmasına rağmen gelişmekte olan erkek larvalar üzerinde öldürücü etki göstermektedir.